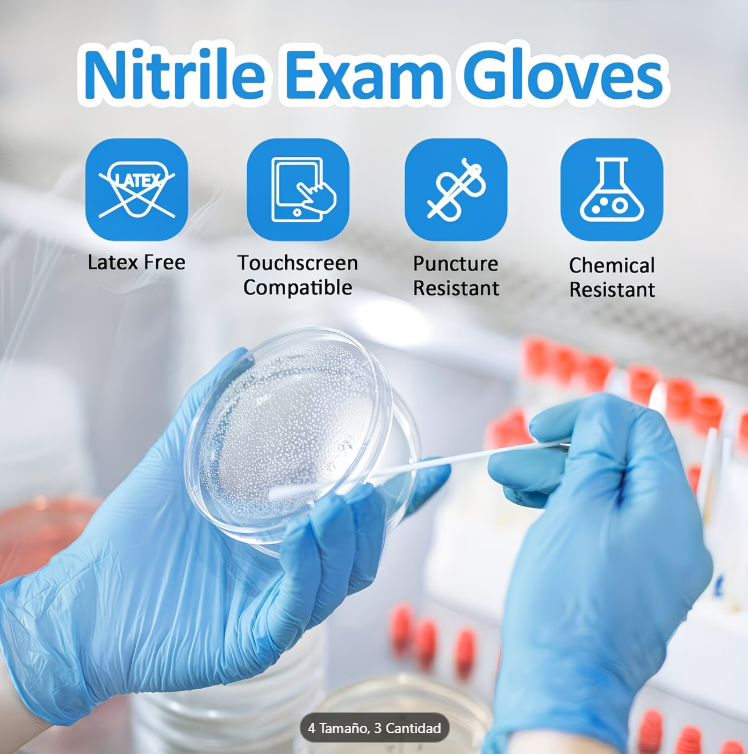
Guantes de Nitrilo

Conoce Nuestros Productos
Microaplicadores Dentales
Microaplicadores Dentales
Precio de oferta
$5.50 USD
Precio habitual
$6.50 USD
Lamina de Goma Dental Dique
Lamina de Goma Dental Dique
Precio de oferta
$5.55 USD
Precio habitual
$7.50 USD
Juego de Herramientas Dentales de Acero Inoxidable 6 pcs
Juego de Herramientas Dentales de Acero Inoxidable 6 pcs
Precio de oferta
$35.00 USD
Precio habitual
$49.00 USD